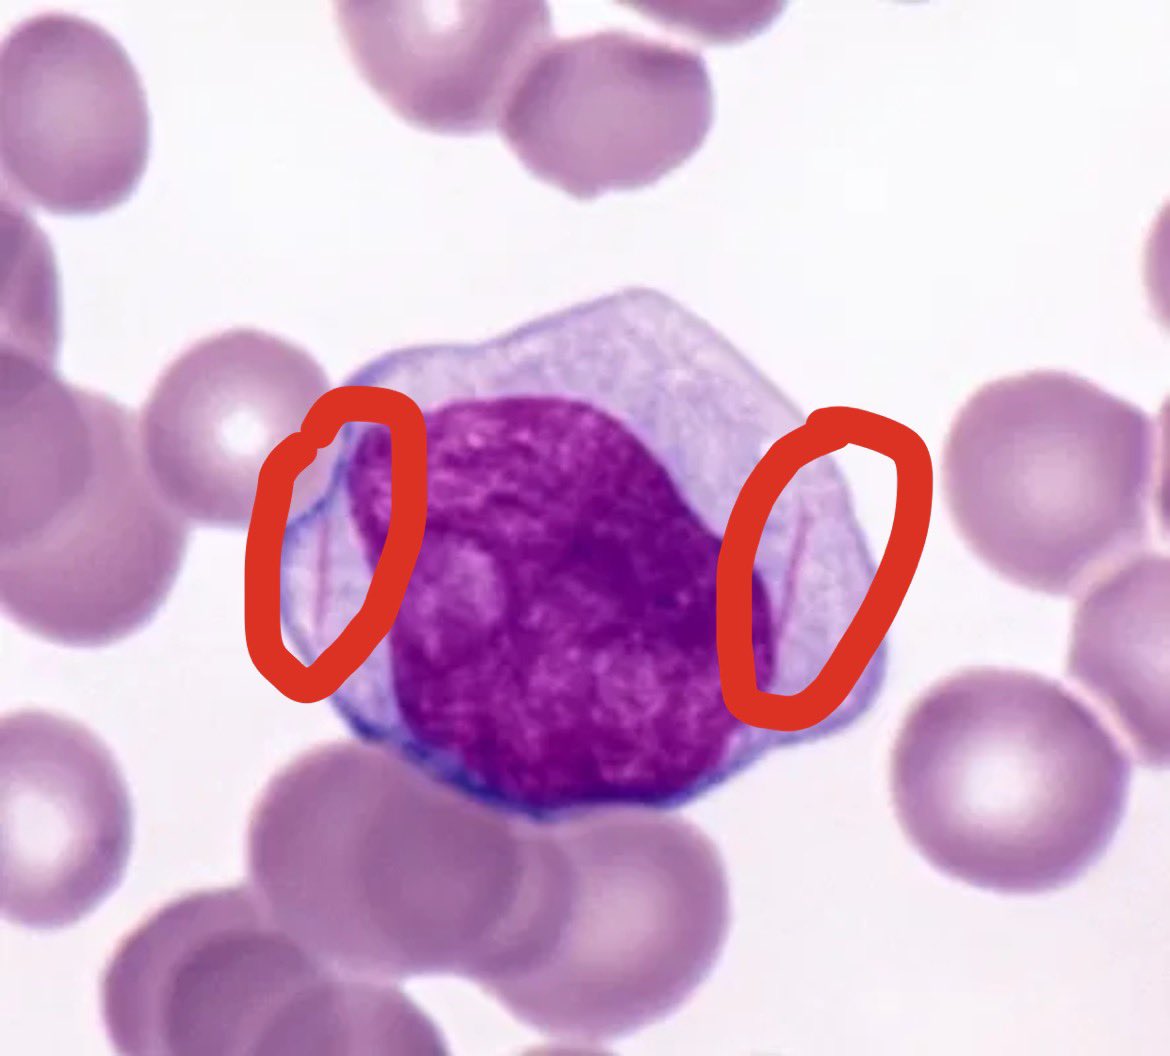
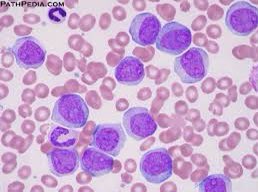

مساء الخير 😍😍😍
اليوم راح اتكلم عن لوكيميا )leukemia )
اليوم راح اتكلم عن لوكيميا )leukemia )
خلونا بالبداية نعرف هو فين الخلل 🧐
هو تراكم حيكون في الخلايا الدم البيضاء(wbc) غير الطبيعية في نخاع العظام..
يعني تتكاثر الخلايا الخبيثه في الدم 🩸
هو تراكم حيكون في الخلايا الدم البيضاء(wbc) غير الطبيعية في نخاع العظام..
يعني تتكاثر الخلايا الخبيثه في الدم 🩸
طيب قبل م ندخل بالعميق لوكيميا مو بس wbc
بس ممكن تكون rbc,platelet
بس اكثر شي تكون في(wbc)🩸
معلومه بس😁🤩🤩
بس ممكن تكون rbc,platelet
بس اكثر شي تكون في(wbc)🩸
معلومه بس😁🤩🤩
طيب هل لها انواع ولا لا؟!🧐
نعم لها انواع 😌
(Acute leukemia )
(chronic leukemia)
نعم لها انواع 😌
(Acute leukemia )
(chronic leukemia)
Acute leukemia -( Acute myeloid leukemia (AML–هنا أمل😂😂😂 )Acute lymphtic leukemia (ALL)كنت عشان احفظها😂😂😂( علي )high malignancy)
chronic leukemia-chronic myeloid leukemia (CML– chronic lymphtic leukemia(CLL )low malignancy )
chronic leukemia-chronic myeloid leukemia (CML– chronic lymphtic leukemia(CLL )low malignancy )
طيب عرفنا انواعها كده خلاص
لا طبعا هل هيا (myeloblast ولا lymphoblast )
حطوو ببالكم لهم مراحل كثيره مرا 😅
myeloblast يعني نشوف (RBC و,platelet) راح يكون اربع انواع من (WBC)(N,B,E,M )
lymphoblast حتكون نوع واحد من( WBC) من اسمها يعني (L)
لا طبعا هل هيا (myeloblast ولا lymphoblast )
حطوو ببالكم لهم مراحل كثيره مرا 😅
myeloblast يعني نشوف (RBC و,platelet) راح يكون اربع انواع من (WBC)(N,B,E,M )
lymphoblast حتكون نوع واحد من( WBC) من اسمها يعني (L)
طبعا الصوره بس للتوضيح قبل م ندخل على كل نوع منهم🤩👆🏻👆🏻👆🏻👆🏻
ACUTE LYMPHOBLASTIC LEUKEMIA (all)
خلونا نتكلم شويا عن👆🏻ونعرف معلومات
هو ورم يكون في خلايا الليمفاوية 🔬يعني لم نسوي blood film حنشوف (lymphoblast)
يكون اكثر شي في الاطفال ،،يكون اكثر عند الذكور ✅
خلونا نتكلم شويا عن👆🏻ونعرف معلومات
هو ورم يكون في خلايا الليمفاوية 🔬يعني لم نسوي blood film حنشوف (lymphoblast)
يكون اكثر شي في الاطفال ،،يكون اكثر عند الذكور ✅
طيب يلا نجي للتشخيص بالتحاليل 💉
اول شي CBC
حنشوف مجموع (WBC ) عالي ولا منخفض ولا طبيعي 🧐
طيب حنشوف كمان Normocytic ،،normochromic anemia)
كمان حنشوف platelet منخفضه
(Thrombocytopenia)
اول شي CBC
حنشوف مجموع (WBC ) عالي ولا منخفض ولا طبيعي 🧐
طيب حنشوف كمان Normocytic ،،normochromic anemia)
كمان حنشوف platelet منخفضه
(Thrombocytopenia)
طيب كمان حنشوف عن كمستري 🤩🤩🤩
Serum uric acid :حيكون عالي
serum LDH:حيكون عالي
hypercalcemia:حيكون برضو الكالسيوم عالي
يعني كلهم في ارتفاع⬆️⬆️⬆️⬆️⬆️⬆️
Serum uric acid :حيكون عالي
serum LDH:حيكون عالي
hypercalcemia:حيكون برضو الكالسيوم عالي
يعني كلهم في ارتفاع⬆️⬆️⬆️⬆️⬆️⬆️
طيب يلا نجي نتكلم عن(ACUTE MYELOGENOUS LEUKEMIA)
نعرف عنها معلومات شويا🤩🤩🤩
سببها طفرات حنتعرف عليها شويا😻
يكون اكثر في البالغين الكبار
يكون اغلب شي عند الذكور✅✅
راح نشوفها في( Myeloblas)
نعرف عنها معلومات شويا🤩🤩🤩
سببها طفرات حنتعرف عليها شويا😻
يكون اكثر في البالغين الكبار
يكون اغلب شي عند الذكور✅✅
راح نشوفها في( Myeloblas)
بالاخير تكلمت بالثريد عن acute اللي يكون فيها البلاست اكثر وتكلمنا عن هو ايش النوع Myeloblatsولاlymphoplas)
وخلصنا ✅✅✅✅✅✅✅✅✅✅
وخلصنا ✅✅✅✅✅✅✅✅✅✅
اللهم علمني ماينفعني وانفعني بما علمتني وزدني علما💓💓💓💓
جاري تحميل الاقتراحات...